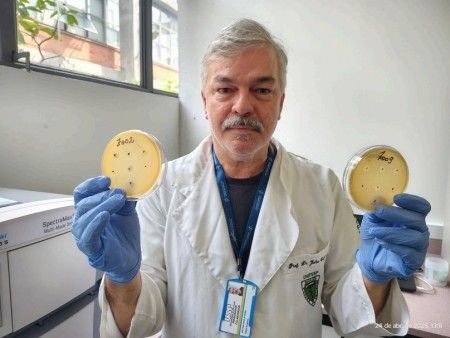

Pesquisa no Brasil descobre mais de 60 vírus que matam bactérias resistentes a antibióticos
Novos vírus podem ajudar a combater bactérias resistentes a antibióticos. Descoberta é de pesquisadores da Unifesp, USP e Cetesb

Larissa Alvarenga
Uma pesquisa brasileira conduzida por centros financiados pela Fapesp, Fundação de Amparo à Pesquisa do Estado de São Paulo, resultou na descoberta de 62 novos tipos de vírus que infectam e matam bactérias.
+ Superbactérias matam mais que Aids e Malária e brasileiro não tem tratamento adequado
O trabalho envolveu o Cepid B3 (Centro de Pesquisa em Biologia de Bactérias e Bacteriófagos), o Projeto Aries (Instituto Paulista de Resistência aos Antimicrobianos) e o Centro de Pesquisa em Alimentos, com participação da Cetesb (Companhia Ambiental do Estado de São Paulo) e do Zoológico de São Paulo.
A iniciativa foi liderada por Julio Cezar Franco, professor da Unifesp (Universidade Federal de São Paulo). As primeiras amostras vieram do Aries e da Cetesb, que coletam material em estações de tratamento de esgoto da Grande São Paulo. Também foram usados microrganismos obtidos em hospitais, aeroportos e áreas de compostagem fornecidas.
Com o material em mãos, Franco começou a isolar os vírus presentes nas amostras e a testá-los contra as bactérias. Para isso, cultivou os microorganismos de interesse em placas repletas de nutrientes até que cobrissem toda a superfície.
+ Por que a fertilidade pode ser influenciada pelas bactérias? Entenda
Em seguida, depositou um pouco de cada amostra com os novos vírus em alguns pontos espaçados. Se o vírus presente na amostra tivesse a capacidade de infectar e matar a bactéria em questão, era possível notar espaços transparentes sobre o “tapete de bactérias”. Esse seria o local onde o vírus matou a bactéria.
O processo foi repetido centenas de vezes e trouxe resultados inéditos: 62 novos vírus.
Segundo o pesquisador, os vírus descobertos poderão ser usados para desenvolver estratégias contra bactérias resistentes a antibióticos, problema comum em hospitais, e também para prevenir contaminações em alimentos.